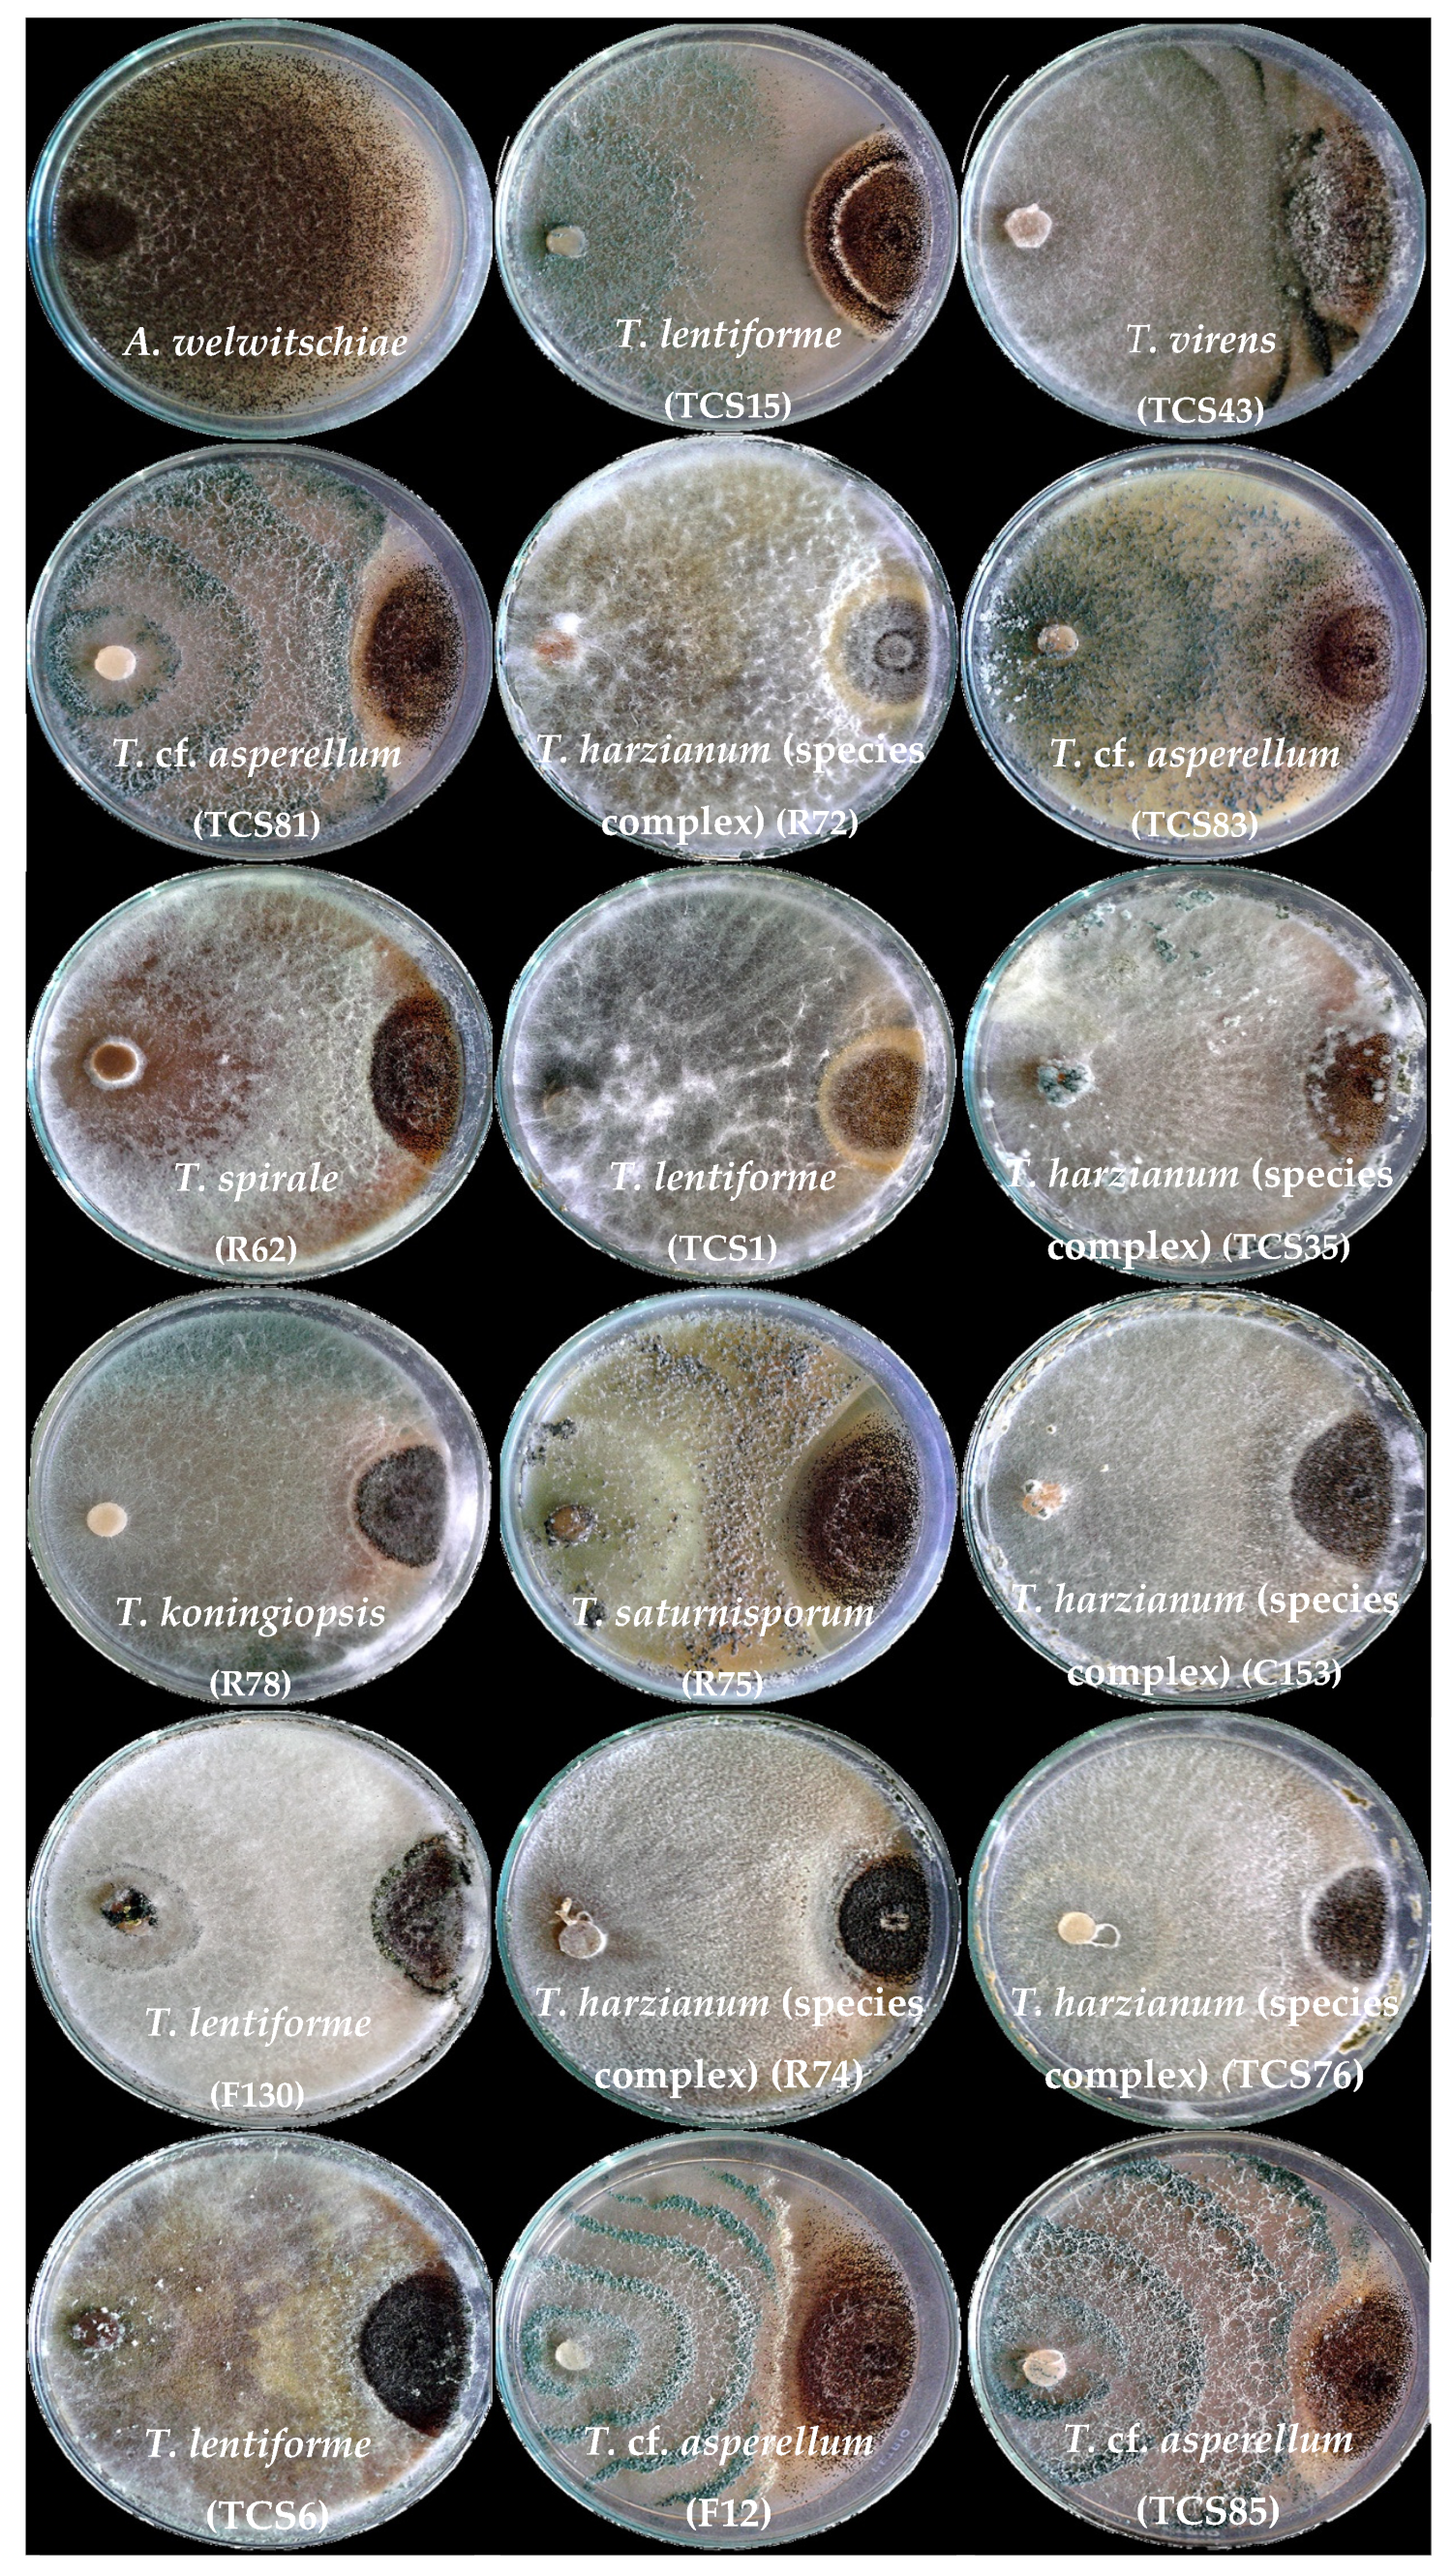
Jof 10 00860 g002

Native and Non-Native Soil and Endophytic Trichoderma spp. from Semi-Arid Sisal Fields of Brazil Are Potential Biocontrol Agents for Sisal Bole Rot Disease
Abstract
1. Introduction
2. Materials and Methods
2.1. Molecular Identification of Trichoderma spp. and A. welwitschiae Isolates
2.2. Spore Suspension of Trichoderma spp. and A. welwitschiae
2.3. Dual Culture Assays with A. welwitschiae and Trichoderma spp.
2.4. Volatile Compounds of Trichoderma spp. on Growth and Sporulation of A. welwitschiae
2.5. Non-Volatile Metabolites of Trichoderma and Their Effect on A. welwitschiae
2.6. Control Assays of Bole Rot Disease Under Greenhouse Conditions
2.6.1. Growth of Sisal Plants
2.6.2. Trichoderma and A. welwitschiae Inoculation Assay in Sisal Plants
2.6.3. Anatomical Analysis of Sisal Bole Tissue
2.7. Data Analysis
3. Results
3.1. Molecular Identification of Trichoderma Isolates and A. welwitschiae
3.2. Dual Culture Assays with Trichoderma and A. welwitschiae
3.3. Effect of Volatile Compounds of Different Species and Isolates of Trichoderma spp. on Growth and Sporulation of A. welwitschiae
3.4. Nonvolatile Compounds (Culture Filtrates) of Trichoderma spp. Against A. welwitschiae
3.5. Bole Rot Control in Sisal Bulbils Under Greenhouse Conditions
3.6. Anatomical Analysis of Sisal Bole Rot Tissue
4. Discussion
5. Conclusions
Supplementary Materials
Author Contributions
Funding
Institutional Review Board Statement
Informed Consent Statement
Data Availability Statement
Acknowledgments
Conflicts of Interest
References
- Nobel, P.S. Remarkable Agaves and Cacti, 1st ed.; Oxford University Press: New York, NY, USA, 1994; pp. 86–87. [Google Scholar]
- Zizumbo-Villarreal, D.; González-Zozaya, F.; Olay-Barrientos, A.; Platas-Ruíz, R.; Cuevas-Sagardí, M.; Almendros-López, L.; Colunga-GarcíaMarín, P. Archaeological evidence of the cultural importance of Agave spp. in pre-Hispanic Colima, Mexico. Econ. Bot. 2009, 63, 288–302. [Google Scholar] [CrossRef]
- Parsons, J.R.; Darling, J.A. Maguey (Agave spp.) utilization in Mesoamerican civilization: A case for precolumbian “Pastoralism”. Bot. Sci. 2000, 66, 81–91. [Google Scholar] [CrossRef]
- Davis, S.C.; Ortiz-Cano, H.G. Lessons from the history of Agave: Ecological and cultural context for valuation of CAM. Ann. Bot. 2023, 132, 819–833. [Google Scholar] [CrossRef] [PubMed]
- Nobel, P.S. Environmental Biology of Agaves and Cacti; Cambridge University Press: New York, NY, USA, 2003; p. 270. [Google Scholar]
- Davis, S.C.; Simpson, J.; Gil-Vega, K.d.C.; Niechayev, N.A.; Tongerlo, E.V.; Castano, N.H.; Dever, L.V.; Búrquez, A. Undervalued potential of crassulacean acid metabolism for current and future agricultural production. J. Exp. Bot. 2019, 70, 6521–6537. [Google Scholar] [CrossRef]
- Pérez-Pimienta, J.A.; López-Ortega, M.G.; Sanchez, A. Recent developments in Agave performance as a drought-tolerant biofuel feedstock: Agronomics, characterization, and biorefining. Biofuel Bioprod. Biorefin. 2017, 11, 732–748. [Google Scholar] [CrossRef]
- Raya, F.T.; Abreu, L.G.F.; Marone, M.P.; Salvador, M.A.; Bressiani, J.A.; Laborde, J.I.R.; Pereira, G.A.G. New Feedstocks for Bioethanol Production: Energy Cane and Agave. In Liquid Biofuels: Bioethanol; Soccol, C.R., Pereira, G.A.G., Dussap, C.G., Vandenberghe, L.P.S., Eds.; Springer: Cham, Switzerland, 2022; Volume 12, pp. 431–455. [Google Scholar]
- Medina, J.C. O Sisal.: Secretaria da Agricultura; Diretoria de Publicidade Agrícola: São Paulo, Brazil, 1954; p. 286. [Google Scholar]
- Soares, A.C.F.; Santos, J.S.; Sousa, R.A.; Barbosa, L.O.; Duarte, E.A.A.; Góes-Neto, A. Sisal: Podridão vermelha e o biocontrole. In Tópicos em Microbiologia Agrícola, 1st ed.; Soares, A.C.F., Evangelista-Barreto, N., Marbach, P.A.S., Eds.; EDUFRB: Cruz das Almas, Brazil, 2020; pp. 157–186. [Google Scholar]
- FAOSTAT. Available online: https://www.fao.org/faostat/en/#data/QCL (accessed on 15 July 2024).
- IBGE-Instituto Brasileiro de Geografia e Estatística. Produção de sisal (Fibra) Brasília, DF: IBGE. 2022. Available online: https://www.ibge.gov.br/explica/producao-agropecuaria/sisal-fibra/ba (accessed on 22 May 2024).
- Marrone, M.P.; Raya, F.T.; Magalhães, E.C.D.; Soares, A.C.F.; Carazzolle, M.F.; Pereira, G.A.G. SISAL: De um passado rústico para um futuro brilhante. In O Semiárido Brasileiro e Suas Especificidades; Oliveira, A.C., Ed.; Editora Atena: Ponta Grossa, Brazil, 2020; pp. 40–57. [Google Scholar]
- Duarte, E.A.A.; Damasceno, C.L.; Oliveira, T.A.S.; Barbosa, L.O.; Martins, F.M.; Silva, J.R.Q.; Lima, T.E.F.; Silva, R.M.; Kato, R.B.; Bortolini, D.E.; et al. Putting the mess in order: Aspergillus welwitschiae (and not A. niger) is the etiological agent of sisal bole rot disease in Brazil. Front. Microbiol. 2018, 9, 1227. [Google Scholar] [CrossRef]
- Raya, F.T.; Quintanilha-Peixoto, G.; Oliveira, A.B.; Marone, M.P.; Reis, W.J.V.; Marques, J.G.O.; Pereira, G.A.G. Molecular epidemiology of sisal bole rot disease suggests a potential phytosanitary crisis in Brazilian production areas. Front. Chem. Eng. 2023, 5, 1174689. [Google Scholar] [CrossRef]
- Lee, S.; An, C.; Xu, S.; Lee, S.; Yamamoto, N. High-throughput sequencing reveals unprecedented diversities of Aspergillus species in outdoor air. Lett. Appl. Microbiol. 2016, 63, 165–171. [Google Scholar] [CrossRef]
- Ismail, M.A. Incidence and significance of black aspergilli in agricultural commodities: A review, with a key to all species accepted to-date. Eur. J. Biol. Res. 2016, 7, 207–222. [Google Scholar] [CrossRef]
- Mousumi, M.; Haridas, M.; Sabu, A. Biological control of black pepper and ginger pathogens, Fusarium oxysporum, Rhizoctonia solani and Phytophthora capsici, using Trichoderma spp. Biocatal. Agric. Biotechnol. 2019, 17, 177–183. [Google Scholar] [CrossRef]
- Barbosa, L.O.; Lima, J.S.; Magalhães, V.C.; Gava, C.A.T.; Soares, A.C.F.; Marbach, P.A.S.; Souza, J.T. Compatibility and combination of selected bacterial antagonists in the biocontrol of sisal bole rot disease. BioControl 2018, 63, 595–605. [Google Scholar] [CrossRef]
- Magalhães, V.C.; Barbosa, L.O.; Andrade, J.P.; Soares, A.C.F.; Souza, J.T.; Marbach, P.A.S. Burkholderia isolates from a sand dune leaf litter display biocontrol activity against the bole rot disease of Agave sisalana. BioControl 2017, 112, 41–48. [Google Scholar] [CrossRef]
- Sousa, J.T.; Silva, A.C.M.; Santos, A.F.J.; Santos, P.O.; Alves, O.S.; Magalhães, V.C.; Marbach, P.A.S.; Loguercio, L.L. Endophytic bacteria isolated from both healthy and diseased Agave sisalana plants are able to control the bole rot disease. Biol. Control 2021, 157, 104575. [Google Scholar] [CrossRef]
- Damasceno, C.L.; Sá, J.O.; Silva, R.M.; Carmo, C.O.; Haddad, L.S.M.; Soares, A.C.F.; Duarte, E.A.A.D. Penicillium citrinum as a Potential Biocontrol Agent for Sisal Bole Rot Disease. J. Agric. Sci. 2019, 11, 206–216. [Google Scholar] [CrossRef]
- Porteous-Álvarez, A.J.; Fernández-Marcos, A.; Ramírez-Lozano, D.; Mayo-Prieto, S.; Cardoza, R.E.; Gutiérrez, S.; Casquero, P.A. Native Trichoderma Isolates from Soil and Rootstock to Fusarium spp. Control and Growth Promotion of Humulus lupulus L. Plantlets. Agriculture 2023, 13, 720. [Google Scholar] [CrossRef]
- Harman, G.E.; Howell, C.E.; Viterbo, A.; Chet, I.; Lorito, M. Trichoderma species—Opportunistic, avirulent plant symbionts. Nat. Rev. Microbiol. 2004, 2, 43–56. [Google Scholar] [CrossRef]
- Stracquadanio, C.; Quiles, J.M.; Meca, J.; Cacciola, S.O. Antifungal Activity of Bioactive Metabolites Produced by Trichoderma asperellum and Trichoderma atroviride in Liquid Medium. J. Fungi 2020, 6, 263. [Google Scholar] [CrossRef]
- Roatti, B.; Perazzolli, M.; Gessler, C.; Pertot, I. Abiotic Stresses Affect Trichoderma harzianum T39-Induced Resistance to Downy Mildew in Grapevine. Phytopathology 2013, 103, 1227–1234. [Google Scholar] [CrossRef]
- Mayo, S.; Gutiérrez, S.; Malmierca, M.G.; Lorenzana, A.; Campelo, M.P.; Hermosa, R.; Casquero, P.A. Influence of Rhizoctonia solani and Trichoderma spp. in growth of bean (Phaseolus vulgaris L.) and in the induction of plant defense-related genes. Front. Plant. Sci. 2015, 6, 685. [Google Scholar] [CrossRef]
- Mukherjee, M.; Mukherjee, P.K.; Horwitz, B.A.; Zachow, C.; Berg, G.; Zeilinger, S. Trichoderma–Plant–Pathogen Interactions: Advances in Genetics of Biological Control. Indian J. Microbiol. 2012, 52, 522–529. [Google Scholar] [CrossRef]
- Druzhinina, I.; Seidl-Seiboth, V.; Herrera-Estrella, A.; Horwitz, B.A.; Kenerley, C.M.; Monte, E.; Murkherjee, P.K.; Zeilinger, S.; Grigoriev, I.V.; Kubicek, C.P. Trichoderma: The genomics of opportunistic success. Nat. Rev. Microbiol. 2011, 9, 749–759. [Google Scholar] [CrossRef] [PubMed]
- Erazo, J.G.; Palacios, S.A.N.; Pastor, N.; Giordano, F.D.; Rovera, M.; Reynoso, M.M.; Venisse, J.S.; Torres, A.M. Biocontrol mechanisms of Trichoderma harzianum ITEM 3636 against peanut brown root rot caused by Fusarium solani RC 386. Biol. Control. 2021, 164, 104774. [Google Scholar] [CrossRef]
- Bolaños, B.T.; Hernández, H.G.; Mejía, E.Z.; García, P.S.; Aguilera, G.M.; Díaz, C.N. Colonización de Trichoderma y Bacillus en Plántulas de Agave tequilana Weber, var. Azul y el Efecto Sobre la Fisiología de la Planta y Densidad de Fusarium. Rev. Mex. Fitopatol. 2014, 32, 62–74. [Google Scholar]
- Sánchez, V.; Rebolledo, O. Especies de Trichoderma en suelos cultivados con Agave tequilana en la región de Los Altos Sur, Jalisco y valoración de su capacidad antagónica contra Thielaviopsis paradoxa. Rev. Mex. Mic. 2010, 32, 11–18. [Google Scholar]
- White, T.J.; Bruns, T.; Lee, S.; Taylor, J.W. Amplification and direct sequencing of fungal ribosomal RNA genes for phylogenetics. In PCR Protocols: A Guide to Methods and Applications; Innis, M.A., Gelfand, D.H., Sninsky, J.J., White, T.J., Eds.; Academic Press: New York, NY, USA, 1990; pp. 315–322. [Google Scholar]
- O’Donnell, K.; Kistler, H.C.; Cigelnik, E.; Ploetz, R.C. Multiple evolutionary origins of the fungus causing Panama disease of banana: Concordant evidence from nuclear and mitochondrial gene genealogies. Proc. Natl. Acad. Sci. USA 1998, 95, 2044–2049. [Google Scholar] [CrossRef]
- Carbone, I.; Kohn, L.M. A method for designing primer sets for speciation studies in filamentous ascomycetes. Mycologia 1999, 91, 553–556. [Google Scholar] [CrossRef]
- Vaz, A.B.M.; Fonseca, P.L.C.; Badotti, F.; Skaltsas, D.; Tomé, L.M.R.; Silva, A.C.; Cunha, M.C.; Soares, M.A.; Santos, V.L.; Oliveira, G.; et al. A multiscale study of fungal endophyte communities of the foliar endosphere of native rubber trees in Eastern Amazon. Sci. Rep. 2018, 8, 16151. [Google Scholar] [CrossRef]
- Sundaramoorthy, S.; Raguchander, T.; Ragupathi, N.; Samiyappan, R. Combinatorial effect of endophytic and plant growth promoting rhizobacteria against wilt disease of Capsicum annum L. caused by Fusarium solani. Biol. Control. 2012, 60, 59–67. [Google Scholar] [CrossRef]
- Guimarãres, G.R.; Ferreira, D.S.; Galvão, C.S.; Mello, S.C.M.; Carvalho, D.D.C. Ação de metabólitos voláteis e não voláteis de Trichoderma harzianum sobre o crescimento de Cladosporium herbarum. Pesq. Agrop. Pernamb. 2016, 21, 7–11. [Google Scholar] [CrossRef]
- Barbosa, L.O. Podridão Vermelha do Sisal: Controle com Trichoderma spp., Escala de Notas e Estudos Histopatológicos. Ph.D. Thesis, Universidade Federal do Recôncavo da Bahia, Cruz das Almas, Brazil, 2019. [Google Scholar]
- Mckinney, H.H. A new system of grading plant diseases. J. Agric. Res. 1923, 26, 195–218. [Google Scholar]
- Johansen, D.A. Plant Microtechnique, 1st ed.; McGraw-Hill Publications Book Company: New York, NY, USA, 1940. [Google Scholar]
- Meira, R.M.S.A.; Martins, F.M. Inclusão de material herborizado em metacrilato para estudos de anatomia vegetal. Rev. Árvore. 2003, 27, 109–112. [Google Scholar] [CrossRef]
- Junqueira, C.U.O. Uso de cortes finos de tecidos na medicina e biologia. Meios Métodos 1990, 66, 167–171. [Google Scholar]
- Carvalho, F.V.; Santana, L.F.; Silva, V.D.A.; Costa, S.L.; Zambotti-Villelae, L.; Colepicolo, P.; Ferraz, C.G.; Ribeiro, P.R. Combination of a multiplatform metabolite profiling approach and chemometrics as a powerful strategy to identify bioactive metabolites in Lepidium meyenii (Peruvian maca). Food Chem. 2021, 364, 130453. [Google Scholar] [CrossRef]
- R Core Team. R: A Language and Environment for Statistical Computing; R Foundation for Statistical Computing: Vienna, Austria, 2024; Available online: https://www.R-project.org/ (accessed on 12 November 2024).
- Köhl, J.; Kolnaar, R.; Ravensberg, W.J. Mode of action of microbial biological control agents against plant diseases: Relevance beyond efficacy. Front. Plant. Sci. 2019, 10, 845. [Google Scholar] [CrossRef] [PubMed]
- Calistru, C.; McLean, M.; Berjak, P. In vitro studies on the potential for biological control of Aspergillus flavus and Fusarium moniliforme by Trichoderma species 1. Macroscopical and microscopical observations of fungal interactions. Mycopathologia 1997, 139, 115–121. [Google Scholar] [CrossRef] [PubMed]
- Vargas-Inciarte, L.; Fuenmayor-Arrieta, Y.; Luzardo-Méndez, M.; Costa-Jardin, M.; Vera, A.; Carmona, A.; Homen-Pereira, M.; Costa-Jardin, P.; San-Blas, E. Use of different Trichoderma species in cherry type tomatoes (Solanum lycopersicum L.) against Fusarium oxysporum wilt in tropical greenhouses. Agro. Costarric. 2019, 43, 85–100. [Google Scholar] [CrossRef]
- Marín-Guirao, J.I.; Rodríguez-Romera, P.; Lupión-Rodríguez, B.; Camacho-Ferre, F.; Tello-Marquina, J.C. Effect of Trichoderma on horticultural seedlings’ growth promotion depending on inoculum and substrate type. J. Appl. Microbiol. 2016, 121, 1095–1102. [Google Scholar] [CrossRef]
- Sharma, V.; Salwan, R.; Sharma, P.N.; Kanwar, S.S. Elucidation of biocontrol mechanisms of Trichoderma harzianum against different plant fungal pathogens: Universal yet host specific response. Int. J. Biol. Macromol. 2017, 95, 72–79. [Google Scholar] [CrossRef]
- Chaverri, P.; Gazis, R.O.; Samuels, G.J. Trichoderma amazonicum, a new endophytic species on Hevea brasiliensis and H. guianensis from the Amazon basin. Mycologia 2011, 103, 139–151. [Google Scholar] [CrossRef]
- Hosseyni-Moghaddam, M.S.; Soltani, J. Bioactivity of endophytic Trichoderma fungal species from the plant family Cupressaceae. Ann. Microbiol. 2013, 64, 753–761. [Google Scholar] [CrossRef]
- Bailey, B.A.; Strem, M.D.; Wood, D. Trichoderma species form endophytic associations within Theobroma cacao trichomes. Mycol. Res. 2009, 113, 1365–1376. [Google Scholar] [CrossRef] [PubMed]
- Bunbury-Blanchette, A.L.; Walker, A.K. Trichoderma species show biocontrol potential in dual culture and greenhouse bioassays against Fusarium basal rot of onion. Biol. Control. 2019, 130, 127–135. [Google Scholar] [CrossRef]
- Elamathi, E.; Malathi, P.; Viswanathan, R.; Ramesh, S.A. Expression analysis on mycoparasitism related genes during antagonism of Trichoderma with Colletotrichum falcatum causing red rot in sugarcane. J. Plant Biochem. Biotechnol. 2018, 27, 351–361. [Google Scholar] [CrossRef]
- Gajera, H.P.; Vakharia, D.N. Molecular and biochemical characterization of Trichoderma isolates inhibiting a phytopathogenic fungi Aspergillus niger Van Tieghem. Phys. Mol. Plant Pathol. 2010, 74, 274–282. [Google Scholar] [CrossRef]
- Basińska-Barczak, A.; Błaszczyk, L.; Szentner, K. Plant Cell Wall Changes in Common Wheat Roots as a Result of Their Interaction with Beneficial Fungi of Trichoderma. Cells 2020, 9, 2319. [Google Scholar] [CrossRef]
- Saxena, A.; Mishra, S.; Ray, S.; Raghuwanshi, R.; Singh, H.B. Differential reprogramming of defense network in Capsicum annum L. plants against Colletotrichum truncatum infection by phyllospheric and rhizospheric Trichoderma strains. J. Plant Grow. Regul. 2020, 39, 751–763. [Google Scholar] [CrossRef]
- Siddaiah, C.N.; Satyanarayana, N.R.; Mudili, V.; Kumar Gupta, V.; Gurunathan, S.; Rangappa, S.; Srivastava, R.K. Elicitation of resistance and associated defense responses in Trichoderma hamatum induced protection against pearl millet downy mildew pathogen. Sci. Rep. 2017, 7, 43991. [Google Scholar] [CrossRef]

| Strain Code | Identification | GeneBank Number | |||
|---|---|---|---|---|---|
| ITS | Tef1 | Cal1 | Habitat | ||
| TCS1 | T. lentiforme | MW579424 | PQ062204 | PQ083839 | Soil from sisal field |
| TCS6 | T. lentiforme | MW579426 | PQ062206 | PQ083841 | Soil from sisal field |
| TCS15 | T. lentiforme | MW579430 | PQ062210 | PQ083845 | Soil from sisal field |
| TCS43 | T. virens | MW579428 | PQ062208 | PQ083843 | Soil from sisal field |
| TCS35 | T. harzianum (species complex) | MW579427 | PQ062207 | PQ083842 | Soil from sisal field |
| TCS76 | T. harzianum (species complex) | MW579429 | PQ062209 | PQ083844 | Soil from sisal field |
| TCS81 | T. cf. asperellum | PQ555284 | PQ569841 | PQ569839 | Guava plant leaf |
| TCS83 | T. cf. asperellum | MW579425 | PQ062205 | PQ083840 | Soil from banana field |
| TCS85 | T. cf. asperellum | PQ555286 | PQ569842 | PQ569840 | Soil from banana field |
| R39 | T. koningiopsis | MW579418 | PQ062198 | PQ083833 | Roots of healthy sisal |
| R62 | T. spirale | MW579419 | PQ062199 | PQ083834 | Roots of healthy sisal |
| R72 | T. harzianum (species complex) | MW579420 | PQ062200 | PQ083835 | Roots of healthy sisal |
| R74 | T. harzianum (species complex) | MW579421 | PQ062201 | PQ083836 | Roots of healthy sisal |
| R75 | T. saturnisporum | MW579422 | PQ062202 | PQ083837 | Roots of healthy sisal |
| R78 | T. koningiopsis | MW579423 | PQ062203 | PQ083838 | Roots of healthy sisal |
| C153 | T. harzianum (species complex) | MW579417 | PQ062195 | PQ058662 | Stem of healthy sisal |
| F12 | T. cf. asperellum | MW579416 | PQ062196 | PQ058663 | Leaves of healthy sisal |
| F130 | T. lentiforme | MW579418 | PQ062197 | PQ058664 | Leaves of healthy sisal |
Disclaimer/Publisher’s Note: The statements, opinions and data contained in all publications are solely those of the individual author(s) and contributor(s) and not of MDPI and/or the editor(s). MDPI and/or the editor(s) disclaim responsibility for any injury to people or property resulting from any ideas, methods, instructions or products referred to in the content. |
© 2024 by the authors. Licensee MDPI, Basel, Switzerland. This article is an open access article distributed under the terms and conditions of the Creative Commons Attribution (CC BY) license (https://creativecommons.org/licenses/by/4.0/).
Share and Cite
Barbosa, L.O.; Conceição, T.D.S.d.; Neves, A.d.O.; Rocha, W.Z.B.; Damasceno, B.S.; Fonseca, P.L.C.; Ribeiro, P.R.; Tome, L.M.R.; Bortolini, D.E.; Martins, F.M.; et al. Native and Non-Native Soil and Endophytic Trichoderma spp. from Semi-Arid Sisal Fields of Brazil Are Potential Biocontrol Agents for Sisal Bole Rot Disease. J. Fungi 2024, 10, 860. https://doi.org/10.3390/jof10120860
Barbosa LO, Conceição TDSd, Neves AdO, Rocha WZB, Damasceno BS, Fonseca PLC, Ribeiro PR, Tome LMR, Bortolini DE, Martins FM, et al. Native and Non-Native Soil and Endophytic Trichoderma spp. from Semi-Arid Sisal Fields of Brazil Are Potential Biocontrol Agents for Sisal Bole Rot Disease. Journal of Fungi. 2024; 10(12):860. https://doi.org/10.3390/jof10120860
Chicago/Turabian StyleBarbosa, Leonardo O., Tainá D. S. da Conceição, Adriana de O. Neves, Wélica Z. B. Rocha, Beatriz S. Damasceno, Paula L. C. Fonseca, Paulo R. Ribeiro, Luis M. R. Tome, Dener E. Bortolini, Fabiano M. Martins, and et al. 2024. "Native and Non-Native Soil and Endophytic Trichoderma spp. from Semi-Arid Sisal Fields of Brazil Are Potential Biocontrol Agents for Sisal Bole Rot Disease" Journal of Fungi 10, no. 12: 860. https://doi.org/10.3390/jof10120860
APA StyleBarbosa, L. O., Conceição, T. D. S. d., Neves, A. d. O., Rocha, W. Z. B., Damasceno, B. S., Fonseca, P. L. C., Ribeiro, P. R., Tome, L. M. R., Bortolini, D. E., Martins, F. M., Raya, F. T., Goes-Neto, A., & Soares, A. C. F. (2024). Native and Non-Native Soil and Endophytic Trichoderma spp. from Semi-Arid Sisal Fields of Brazil Are Potential Biocontrol Agents for Sisal Bole Rot Disease. Journal of Fungi, 10(12), 860. https://doi.org/10.3390/jof10120860

